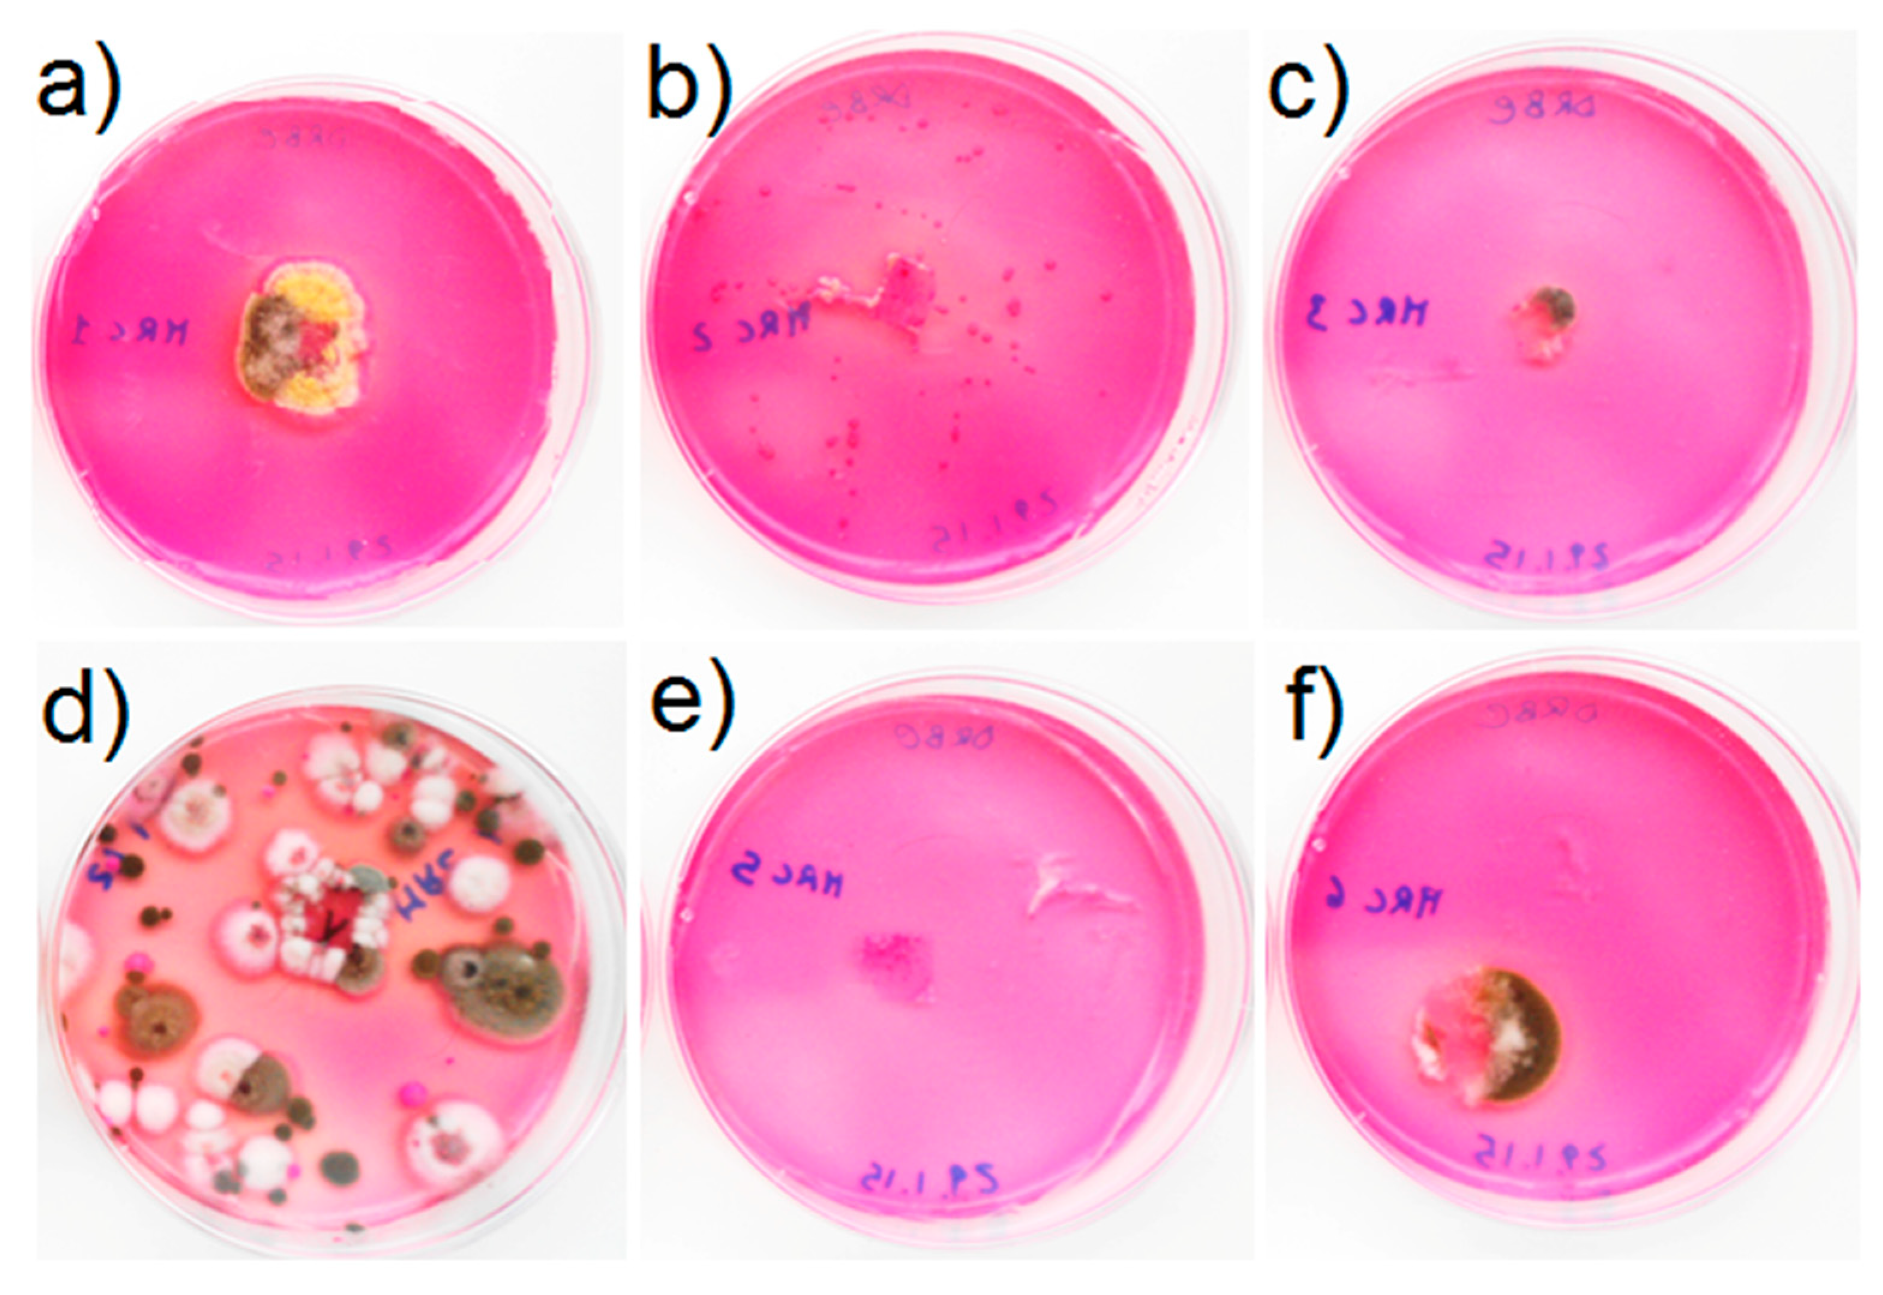
Applsci 10 05106 g007

Multidisciplinary Approach to Characterize Archaeological Materials and Status of Conservation of the Roman Thermae of Reggio Calabria Site (Calabria, South Italy)
Abstract
Featured Application
Abstract
1. Introduction
2. Archaeological Setting
3. Sampling
3.1. Archaeological Stone Materials
3.2. Microbiological Sampling
4. Analytical Methods and Laboratory Procedures
4.1. Archaeometric and Diagnostic Analysis
4.2. Microbiological Analysis
5. Results and Discussion
5.1. Archaeometric and Diagnostic Analysis
5.2. Characterization of Archaeological Stone Materials by XRD
5.3. Microbiological Analysis
5.3.1. Epifluorescence Microscope Observations
5.3.2. Cultural Analysis
6. Conclusions
- Overall, all the sampled stone materials show a good state of conservation from a textural point of view, except for the presence of a superficial patina.
- According to the different types of materials identified, the sedimentary samples (i.e., white, pinkish and greyish tesserae), coming from the central area of the thermal bath having a mosaic floor, show more marked alteration forms compared to the tesserae of volcanic origin (i.e., black). Unlike sedimentary samples, volcanic ones do not have superficial alteration layers, such as patinas.
- By comparing the light colored and greyish tesserae and all sedimentary rocks, it is possible to detect some differences in terms of alteration forms, mainly attributable to biological colonization. Many of these are replacement tesserae and show superficial patinas with lower thicknesses than the original ones.
- In some replacement tesserae, the bedding mortar is much more degraded than that found in some original tesserae.
- As for the samples taken in the caldarium room, including both brick, marble and mortar, they show an overall good state of conservation with slighter superficial patinas compared to those found in specimens sampled in the central compartment with mosaic. Additionally, the mortar is intact, well preserved and rich in fragments of cocciopesto that surely increased its resistance and limited the degradation.
- Biological colonization resulted to be one of the main problems causing esthetical (coverage of surfaces), mechanical (endolithic colonization) and chemical deterioration patina formation and alteration layers ranging from 200 to 500 µm depending on the nature of the colonized material. In fact, volcanic rock (dark tesserae) is less affected by biological attack, followed by compact sedimentary calcareous stone, while those stones with cracks and fissurations are affected not only by a biological patina on the surface but also by a colonization of endolithic microorganisms, mainly black fungi.
Author Contributions
Funding
Conflicts of Interest
References
- Alberghina, M.F.; Casanova Municchia, A.; Germinario, G.; Macchia, A.; Matteini, M.; Milazzo, G.; Ruffolo, S.A.; Sabbatini, L.; Schiavone, S.; Sodo, A.; et al. A multi-analitycal approach to adress a sustanaible conservation of the main marble portal of the Monreale Cathedral. Int. J. Conserv. Sci. 2020, 11, 353–362. [Google Scholar]
- Randazzo, L.; Collina, M.; Ricca, M.; Barbieri, L.; Bruno, F.; Arcudi, A.; La Russa, M.F. Damage Indices and Photogrammetry for Decay Assessment of Stone-Built Cultural Heritage: The Case Study of The San Domenico Church Main Entrance Portal (South Calabria, Italy). Sustainability 2020, 12, 5198. [Google Scholar] [CrossRef]
- Ricca, M.; Galli, G.; Ruffolo, S.A.; Sacco, A.; Aquino, M.; La Russa, M.F. An archaeometric approach of historical mortars taken from Foligno City (Umbria, Italy): News insight of Roman Empire in Italy. Archaeol. Anthrop. Sci. 2019, 11, 2649–2657. [Google Scholar] [CrossRef]
- Ricca, M.; Le Pera, E.; Licchelli, M.; Macchia, A.; Malagodi, M.; Randazzo, L.; Rovella, N.; Ruffolo, S.A.; Weththimuni, M.L.; La Russa, M.F. The CRATI project: New insights on the consolidation of salt weathered stone and the case study of San Domenico Church in Cosenza (South Calabria, Italy). Coatings 2019, 9, 330. [Google Scholar] [CrossRef]
- La Russa, M.F.; Ricca, M.; Cerioni, A.M.; Chilosi, M.G.; Comite, V.; De Santis, M.; Rovella, N.; Ruffolo, S.A. The colors of the Fontana di Trevi: An analytical approach. Int. J. Archit. Herit. 2018, 12, 1. [Google Scholar] [CrossRef]
- Rovella, N.; Arcudi, A.; Crupi, V.; La Russa, M.F.; Majolino, D.; Osanna, M.; Pace, R.; Ruffolo, S.A.; Ricca, M.; Ruggieri, N.; et al. Tituli Picti in the archaeological site of Pompeii: Diagnostic analysis and conservation strategies. Eur. Phys. J. Plus 2018, 133, 539. [Google Scholar] [CrossRef]
- Ruffolo, S.A.; La Russa, M.F.; Ricca, M.; Belfiore, C.M.; Macchia, A.; Comite, V.; Pezzino, A.; Crisci, G.M. New insights on the consolidation of salt weathered limestone: The case study of Modica stone. Bull. Eng. Geol. Environ. 2017, 76, 11–20. [Google Scholar] [CrossRef]
- La Russa, M.F.; Ruffolo, S.A.; Álvarez de Buergo, M.; Ricca, M.; Belfiore, C.M.; Pezzino, A.; Crisci, G.M. The behaviour of consolidated Neapolitan yellow Tuff against salt weathering. Bull. Eng. Geol. Environ. 2017, 76, 115–124. [Google Scholar] [CrossRef]
- Di Turo, F.; Proietti, C.; Screpanti, A.; Fornasier, M.F.; Cionni, I.; Favero, G.; De Marco, A. Impacts of air pollution on cultural heritage corrosion at European level: What has been achieved and what are the future scenarios. Environ. Pollut. 2016, 218, 586–594. [Google Scholar] [CrossRef]
- Moropoulou, A.; Labropoulos, K.C.; Delegou, E.T.; Karoglou, M.; Bakolas, A. Non-destructive techniques as a tool for the protection of built cultural heritage. Constr. Build. Mater. 2013, 48, 1222–1239. [Google Scholar] [CrossRef]
- La Russa, M.F.; Ruffolo, S.A.; Belfiore, C.M.; Aloise, P.; Rovella, N.; Randazzo, L.; Pezzino, A.; Montana, G. Study of the effects of salt crystallisation on degradation of limestone rocks. Period. Miner. 2013, 82, 113–127. [Google Scholar]
- La Russa, M.F.; Belfiore, C.M.; Comite, V.; Barca, D.; Bonazza, A.; Ruffolo, S.A.; Crisci, G.M.; Pezzino, A. Geochemical study of black crusts as a diagnostic tool in cultural heritage. App. Phys. A 2013, 113, 1151–1162. [Google Scholar] [CrossRef]
- Belfiore, C.M.; Fichera, G.V.; La Russa, M.F.; Pezzino, A. The Baroque architecture of Scicli (south-eastern Sicily): Characterization of degradation materials and testing of protective products. Period. Miner. 2012, 81. [Google Scholar] [CrossRef]
- Doehne, E.; Price, C.A. Stone Conservation: An Overview of Current Research, 2nd ed.; The Getty Conservation Institute: Los Angeles, CA, USA, 2010; p. 176. [Google Scholar]
- Zehnde, K.; Schoch, O. Efflorescence of mirabilite, epsomite and gypsum traced by automated monitoring on-site. J. Cult. Herit. 2009, 10, 319–330. [Google Scholar] [CrossRef]
- Grossi, C.M.; Brimblecombe, P. Effect of long-term changes in air pollution and climate on the decay and blackening of European Stone buildings. In Building Stone Decay: From Diagnosis to Conservation, Geological Society, Special Publication, N. 271; Prikryl, R., Smith, B.J., Eds.; The Geological Society of London: London, UK, 2007; pp. 117–130. [Google Scholar]
- Cardell, C.; Delalieux, F.; Roumpopoulos, K.; Moropoulou, A.; Auger, F.; VanGrieken, R. Salt-induced decay in calcareous stone monuments and buildings in a marine environment in SW France. Constr. Build. Mater. 2003, 17, 165–179. [Google Scholar] [CrossRef]
- Primerano, P.; Marino, G.; Di Pasquale, S.; Mavilia, L.; Corigliano, F. Possible alteration of monuments caused by Primerano particles emitted into the atmosphere carrying strong primary acidity. Atmos. Environ. 2000, 34, 3889–3896. [Google Scholar] [CrossRef]
- Diakumaku, E.; Gorbushina, A.A.; Krumbein, W.E.; Panina, L.; Soukharjevski, S. Black fungi in marble and limestones an aesthetical, chemical and physical problem for the conservation of monuments. Sci. Total Environ. 1995, 167, 295–304. [Google Scholar] [CrossRef]
- Amoroso, G.G.; Fassina, V. Stone Decay and Conservation: Atmospheric Pollution, Cleaning Consolidation and Protection; Elsevier: Amsterdam, The Netherlands, 1983; p. 474. [Google Scholar]
- Del Monte, M.; Sabbioni, C.; Vittori, O. Airborne carbon particles and marble deterioration. Atmos. Environ. 1981, 15, 645–665. [Google Scholar] [CrossRef]
- Guillitte, O. Bioreceptivity: A new concept for building ecology studies. Sci. Total Environ. 1995, 167, 215–220. [Google Scholar] [CrossRef]
- Urzì, C. Microbial deterioration of rocks and marble monuments of the Mediterranean basin: A review. Corros. Rev. 2004, 22, 441–457. [Google Scholar] [CrossRef]
- UNI 11182:2006 Beni Culturali—Materiali Lapidei Naturali Ed Artificiali—Descrizione Della Forma Di Alterazione—Termini E Definizioni ICS: [01.020] [91.100.15] Commissioni Tecniche: [Beni Culturali—NORMAL] Aree Tematiche: [PRODOTTI FINITI]. Available online: http://store.uni.com/catalogo/uni-11182-2006/ (accessed on 26 June 2020).
- ICOMOS-ISCS. Illustrated Glossary on Stone Deterioration Patterns. Available online: http://iscs.icomos.org/glossary.html (accessed on 26 June 2020).
- Pinna, D. Coping with Biological Growth on Stone Heritage Objects. Methods, Products, Applications, and Perspectives; Apple Academic Press: Palm Bay, FL, USA, 2017; ISBN 9781771885324. [Google Scholar]
- Pinna, D.; Salvadori, B.; Galeotti, M. Monitoring the performance of innovative and traditional biocides mixed with consolidants and water-repellents for the prevention of biological growth on stone. Sci. Total Environ. 2012, 423, 132–141. [Google Scholar] [CrossRef] [PubMed]
- Ruffolo, S.A.; De Leo, F.; Ricca, M.; Arcudi, A.; Silvestri, C.; Bruno, L.; Urzì, C.; La Russa, M.F. Medium-term in situ experiment by using organic biocides and titanium dioxide for the mitigation of microbial colonization on stone surfaces. Int. Biodeter. Biodegr. 2017, 123, 17–26. [Google Scholar] [CrossRef]
- Andronico, E.; Micalizzi, C.; Palmeri, S.; Repaci, G.; Triscari, M. Reggio Calabria: Il pavimento musivo delle terme romane. Studio per un intervento di restauro. In Scienza e Beni Culturali XVIII. Atti del Convegno di Studi Bressanone, a Cura di Guido Biscontin e Guido Driussi; Arcadia: Venezia, Italy, 2002. [Google Scholar]
- Amici, C.M. Le Terme romane di Reggio Calabria, rilievo ed analisi tecnica. Quad. Dip. PAU Univ. Reggio Calabria Fac. Archit. 1992, 1, 9–14. [Google Scholar]
- Fiorelli, G. Reggio Calabria, Avanzi di edificio termale scoperti in Piazza delle Caserme. Rapporto del can. In Notizie degli Scavi di Antichità; 1886; pp. 459–460. [Google Scholar]
- Balmelle, C.; Prudhomme, R. Le Décor Geometrique de la Mosaique Romaine: Répertoire Graphique et Descriptif des Compositions Linéaires et Isotropes, 1st ed.; Picard: Paris, France, 1985. [Google Scholar]
- Urzì, C.; De Leo, F. Sampling with adhesive tape strips: An easy and rapid method to monitor microbial colonization on monument surfaces. J. Microbiol. Methods 2001, 44, 1–11. [Google Scholar] [CrossRef]
- Pitt, J.I. A Laboratory Guide to Common Penicillium Species. Commonwealth Scientific and Industrial Research Organization; Division of Food Processing: North Ryde, Australia, 1991. [Google Scholar]
- De Hoog, G.S.; Guarro, J.; Gené, J.; Figueras, M.J. Atlas of Clinical Fungi, 2nd ed.; Centraalbureau voor Schimmelcultures: Delft, The Netherlands, 2000. [Google Scholar]
- Samson, R.A.; Hoekstra, E.S.; Frisvad, J.C.; Filtenborg, O. Introduction to Food-Borne Fungi; Centraalbureau voor Schimmelcultures: Delft, The Netherlands, 1996. [Google Scholar]
- Domsch, K.H.; Gams, W.; Anderson, T.H. Compendium of Soil Fungi; Academic Press: London, UK, 1980. [Google Scholar]
- Folk, R.L. Practical Petrographic Classification of Limestones. AAPG Bull. 1959, 43, 1–38. [Google Scholar]
- Dunham, R.J. Classification of carbonate rocks according to depositional texture. Classification of Carbonate Rocks. Am. Assoc. Pet. Geol. Mem. 1962, 1, 108–121. [Google Scholar]
- Belfiore, C.M.; Ricca, M.; La Russa, M.F.; Ruffolo, S.A.; Galli, G.; Barca, D.; Malagodi, M.; Vallefuoco, M.; Sprovieri, M.; Pezzino, A. Provenance study of building and statuary marbles from the Roman archaeological site of “Villa dei Quintili” (Rome, Italy). Ital. J. Geosci. 2016, 135, 236–249. [Google Scholar] [CrossRef]
- Whitbread, I.K. Greek Transport Amphorae. A Petrological and Archaeological Study; The British School at Athens: Athens, Greece, 1995. [Google Scholar]
- Rovella, N.; Comite, V.; Ricca, M. The methodology of investigation on red-and black-figured pottery of unknown provenance. Int. J. Conserv. Sci. 2016, 72, 954–964. [Google Scholar]
- Kreimeyer, R. Some notes on the Firing Colour of Clay Bricks. Appl. Clay Sci. 1987, 2, 175–183. [Google Scholar] [CrossRef]
- Whitney, D.L.; Evans, B.W. Abbreviations for names of rock-forming minerals. Am. Mineral. 2010, 95, 185–187. [Google Scholar] [CrossRef]

| Archaeological Stone Materials | ||
|---|---|---|
| Sample ID | Sampling Area | Type |
| TTB1 | Floor mosaic—sampling in an area with East exposure | White mosaic’s tessera |
| TTB2 | Floor mosaic—sampling in an area with East exposure | White mosaic’s tessera |
| TTB3 | Floor mosaic—sampling in an area with South exposure | White mosaic’s tessera |
| TTB4 | Floor mosaic—sampling in an area with South exposure | White mosaic’s tessera |
| TTB5 | Floor mosaic—sampling in an area with West exposure | White mosaic’s tessera |
| TTB6 | Floor mosaic—sampling in an area with West exposure | White mosaic’s tessera |
| TTR1 | Floor mosaic—sampling in an area with North exposure | Pinkish mosaic’s tessera |
| TTR2 | Floor mosaic—sampling in an area with North exposure | Pinkish mosaic’s tessera |
| TTRi1 | Floor mosaic—sampling in an area with North exposure | Pinkish mosaic’s tessera * |
| TTGi1 | Floor mosaic—sampling in an area with North exposure | Greyish mosaic tessera * |
| TTBi1 | Floor mosaic—sampling in the central area | White mosaic’s tessera * |
| TTNi1 | Floor mosaic—sampling in the central area | Black mosaic’s tessera * |
| TTN1 | Floor mosaic—sampling in an area with East exposure | Black mosaic’s tessera |
| TTN2 | Floor mosaic—sampling in an area with South exposure | Black mosaic’s tessera |
| TTN3 | Floor mosaic—sampling in an area with West exposure | Black mosaic’s tessera |
| TTN4 | Floor mosaic—sampling in an area with North exposure | Black mosaic’s tessera |
| TBI1 | Floor mosaic—sampling in an area with East exposure | White mosaic’s tessera * |
| TBI2 | Floor mosaic—sampling in an area with West exposure | White mosaic’s tessera * |
| TLM1 | Calidarium—sampling in an area with South exposure | Floor slab in veined white marble |
| TLM2 | Calidarium—sampling in an area with South exposure | Floor slab in veined white marble |
| TL1 | Calidarium—sampling in an area with South exposure near the entrance stairs | Brick fragment |
| TL2 | Calidarium—sampling in an area with South exposure on an inner wall | Brick fragment |
| TL3 | Calidarium—sampling on fictile tubules | Brick fragment |
| TL4 | Calidarium—sampling on fictile tubules | Brick fragment |
| TC1 | Calidarium—sampling on a concrete base | Concrete base |
| TL5 | Wall structure adjacent to the mosaic, Westside exposure | Brick fragment |
| TL6 | Wall structure adjacent to the mosaic, Westside exposure | Brick fragment |
| TL8 | Wall structure adjacent to the mosaic, Westside exposure | Brick fragment |
| Biological Samples | ||
|---|---|---|
| Sample ID | Sampling Area | Type of Colonization |
| MRC1 | Floor mosaic—Untreated area (North exposure), in correspondence of original white tesserae | Greenish to dark green patina |
| MRC2 | Floor mosaic—Area treated with 2% Rocima™ 103 (North exposure), in correspondence of original white tesserae | No apparent colonization on the surface, but visible between the tesserae |
| MRC3 | Floor mosaic—Untreated area, seafront, in correspondence of non-original white tesserae | Biological patina |
| MRC4 | Floor mosaic—Restored area, seafront, in correspondence of cemented area | Biological patina |
| MRC5 | Floor mosaic—External area treated with 2% Rocima™ 103 (North exposure), in correspondence of original white tesserae | Light greyish patina |
| MRC6 | Floor mosaic—Untreated internal area (North exposure), in correspondence of original white tesserae | Heavy black patina |
| Tesserae | ||||
| Group | Sample ID | Type | Classification | Mineralogical phases by XRD |
| I | TTB1 | Sedimentary | Calcarenite (biomicrites/wackestones) | Cal; Qz |
| TTB2 | Cal; Qz | |||
| TTB3 | Cal | |||
| TTB4 | Cal | |||
| TTB5 | Cal | |||
| TTB6 | Cal; Qz; Ab | |||
| II | TTBi1 | Sedimentary | Calcarenite (intrasparite/packstone) | Cal; Qz |
| TBI1 | Calcarenite (biomicrites/wackestones) | Cal | ||
| TBI2 | Calcarenite (biomicrites/wackestones) | Cal | ||
| III | TTN1 | Volcanic | Effusive igneous rock | Cal; Sa; Hbl; Cpx; Fo |
| TTN2 | Cal; Or; Sa; Cpx | |||
| TTN3 | Cal; Ab; Cpx | |||
| TTN4 | Cal; Cpx; Fo; Sa; Hbl | |||
| IV | TTNi1 | Sedimentary | Calcarenite (biomicrites/wackestones) | Cal; Qz |
| V | TTGi1 | Sedimentary | Calcarenite (biomicrites/wackestones) | Cal; Qz; Ab |
| VI | TTR1 | Sedimentary | Calcarenite (pelsparite/packstone) | Cal |
| TTR2 | Calcarenite (intrasparite/packstone) | Cal; Qz | ||
| VII | TTRi1 | Sedimentary | Calcarenite (biomicrite/mudstone) | Cal; Qz |
| Veined white marble | ||||
| Group | Sample ID | Type | Classification | Mineralogical phases by XRD |
| VIII | TLM1 | Metamorphic | White marble | Cal; Qz |
| TLM2 | Cal | |||
| Brick fragment | ||||
| Group | Sample ID | Type | Mineralogical phases by XRD | |
| IX | TL1 | Brick | Cal; Qz; Ab; Di | |
| TL2 | Cal; Qz; Ab; Ilt | |||
| TL3 | Cal; Qz; Di; Gh | |||
| TL4 | Cal; Qz; Ab; Ilt | |||
| TL5 | Cal; Qz; Ab; Ilt | |||
| TL6 | Cal; Qz; Ab; Ilt | |||
| TL8 | Cal; Qz; Ab; Ilt; Di; Gh | |||
| Concrete base | ||||
| Group | Sample ID | Type | Mineralogical phases by XRD | |
| X | TC1 | Mortar | Cal; Qz; Ab | |
| Sample ID | Filamentous Fungi | Yeasts | Algae and/or Cyanobacteria | Bacteria |
|---|---|---|---|---|
| MRC1 | + | + | +++ | - |
| MRC2 | - | - | + | ++++ |
| MRC3 | ++ | + | +++ | ++ |
| MRC4 | +++ | + | +++ | ++ |
| MRC5 | + | - | - | - |
| MRC6 | +++ | - | ++ | - |
| Groups | Sample ID | ||||||
|---|---|---|---|---|---|---|---|
| Preliminary Identification | MRC1 | MRC2 | MRC3 | MRC4 | MRC5 | MRC6 | |
| Fungi | Alternaria sp. | + | - | - | + | - | + |
| Cladosporium sp. | - | - | - | + | + | + | |
| Aspergillus sp. | + | - | - | - | - | - | |
| Trichosporon sp. | - | - | + | + | - | - | |
| Phoma sp. | - | - | - | - | - | + | |
| Acremonium sp. | + | - | + | - | - | - | |
| Coniosporium apollinis | + | - | - | + | - | - | |
| ni yeasts | + | - | - | - | - | - | |
| Algae and/or Cyanobacteria | ni unicellular | +++ | + | ++ | +++ | ++ | - |
| ni filamentous | - | - | ++ | + | - | - | |
© 2020 by the authors. Licensee MDPI, Basel, Switzerland. This article is an open access article distributed under the terms and conditions of the Creative Commons Attribution (CC BY) license (http://creativecommons.org/licenses/by/4.0/).
Share and Cite
Ricca, M.; Urzì, C.E.; Rovella, N.; Sardella, A.; Bonazza, A.; Ruffolo, S.A.; De Leo, F.; Randazzo, L.; Arcudi, A.; La Russa, M.F. Multidisciplinary Approach to Characterize Archaeological Materials and Status of Conservation of the Roman Thermae of Reggio Calabria Site (Calabria, South Italy). Appl. Sci. 2020, 10, 5106. https://doi.org/10.3390/app10155106
Ricca M, Urzì CE, Rovella N, Sardella A, Bonazza A, Ruffolo SA, De Leo F, Randazzo L, Arcudi A, La Russa MF. Multidisciplinary Approach to Characterize Archaeological Materials and Status of Conservation of the Roman Thermae of Reggio Calabria Site (Calabria, South Italy). Applied Sciences. 2020; 10(15):5106. https://doi.org/10.3390/app10155106
Chicago/Turabian StyleRicca, Michela, Clara Enza Urzì, Natalia Rovella, Alessandro Sardella, Alessandra Bonazza, Silvestro Antonio Ruffolo, Filomena De Leo, Luciana Randazzo, Anna Arcudi, and Mauro Francesco La Russa. 2020. "Multidisciplinary Approach to Characterize Archaeological Materials and Status of Conservation of the Roman Thermae of Reggio Calabria Site (Calabria, South Italy)" Applied Sciences 10, no. 15: 5106. https://doi.org/10.3390/app10155106
APA StyleRicca, M., Urzì, C. E., Rovella, N., Sardella, A., Bonazza, A., Ruffolo, S. A., De Leo, F., Randazzo, L., Arcudi, A., & La Russa, M. F. (2020). Multidisciplinary Approach to Characterize Archaeological Materials and Status of Conservation of the Roman Thermae of Reggio Calabria Site (Calabria, South Italy). Applied Sciences, 10(15), 5106. https://doi.org/10.3390/app10155106

